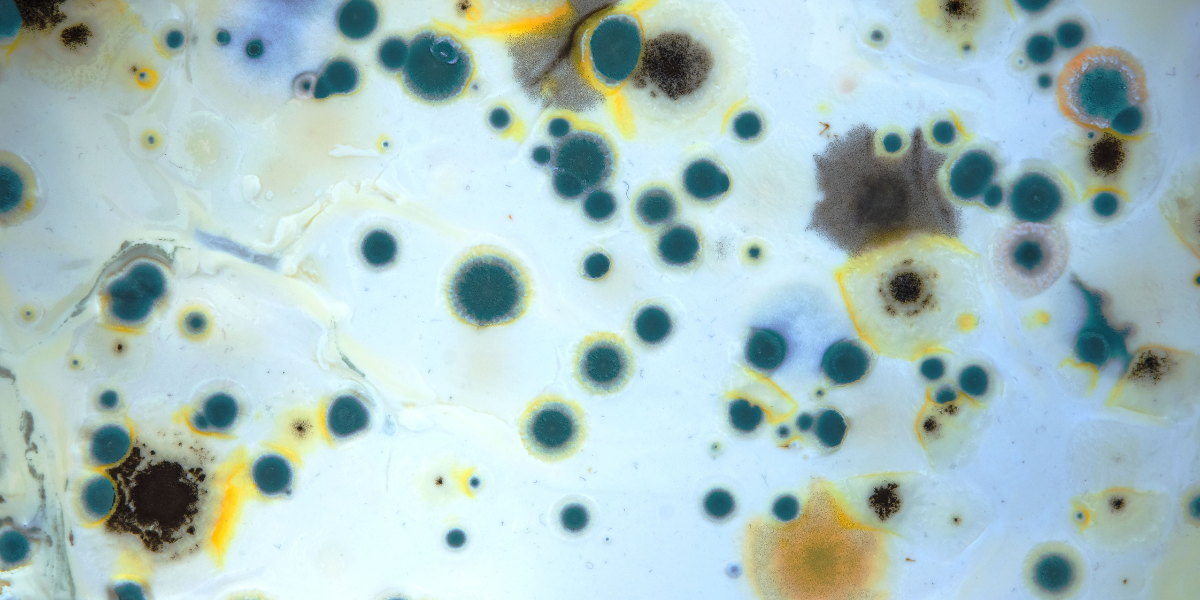

January 16, 2024
When to Seek Professional Odor Removal
No matter how clean our homes or workplaces are, there will always be instances when unpleasant odors arise. From cooking smells lingering in the kitchen to pet accidents on the carpet, we all encounter foul odors from t...